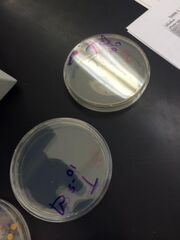
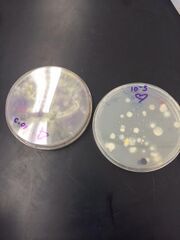

Uploads by Kaitlin E. Kudlac
From OpenWetWare
Jump to navigationJump to search
This special page shows all uploaded files.
| Date | Name | Thumbnail | Size | Description |
|---|---|---|---|---|
| 23:52, 9 March 2014 | Bacteria 5.png (file) |  |
19 KB | |
| 23:51, 9 March 2014 | Bacteria 4.png (file) |  |
25 KB | |
| 23:51, 9 March 2014 | Bacteria 3.png (file) | |
21 KB | |
| 23:50, 9 March 2014 | Bacteria 2.png (file) | |
20 KB | |
| 23:50, 9 March 2014 | Bacteria 1.png (file) |  |
18 KB | |
| 23:37, 9 March 2014 | Serial dilution.png (file) |  |
24 KB | |
| 23:31, 9 March 2014 | Top organisms.png (file) |  |
29 KB | |
| 23:29, 9 March 2014 | Middle organisms.png (file) |  |
25 KB | |
| 23:27, 9 March 2014 | Bottom level organisms 2. png (file) |  |
25 KB | |
| 23:26, 9 March 2014 | Bottom organism 1.png (file) |  |
29 KB | |
| 23:13, 9 March 2014 | Hay infusion overall.png (file) |  |
28 KB | |
| 23:12, 9 March 2014 | Hay infusion top.png (file) |  |
32 KB | |
| 23:04, 9 March 2014 | Overall transect picture.png (file) |  |
189 KB | |
| 23:00, 9 March 2014 | Overall transect picture.jpg (file) |  |
189 KB |